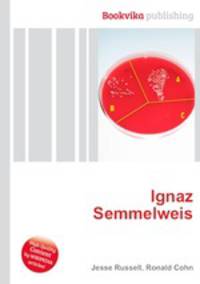
Ignaz Semmelweis

Поиск книг, учебников, пособий в онлайн-магазинах
Ignaz Semmelweis
Автор: Jesse Russell,Ronald Cohn, 108 стр., издатель: "Книга по Требованию", ISBN: 978-5-5094-5699-2High Quality Content by WIKIPEDIA articles! Ignaz Philipp Semmelweis (July 1, 1818 – August 13, 1865) (born Ignac Fulop Semmelweis) was a Hungarian physician now known as an early pioneer of antiseptic procedures. Described as the "savior of mothers", Semmelweis discovered that the incidence of puerperal fever could be drastically cut by the use of hand disinfection in obstetrical clinics. Puerperal fever was common in mid-19th-century hospitals and often fatal, with mortality at 10%–35%. Semmelweis postulated the theory of washing with chlorinated lime solutions in 1847 while working in Vienna General Hospital's First Obstetrical Clinic, where doctors' wards had three times the mortality of midwives' wards. He published a book of his findings in Etiology, Concept and Prophylaxis of Childbed Fever. Данное издание представляет собой компиляцию сведений, находящихся в свободном доступе в среде Интернет в целом, и в информационном сетевом ресурсе "Википедия" в частности. Собранная по...
Рейтинг книги: 



 5 из 5, 2 голос(-ов).
5 из 5, 2 голос(-ов).




 5 из 5, 2 голос(-ов).
5 из 5, 2 голос(-ов).




